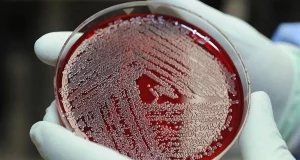
Мікропластик вдалося виявити навіть у крові людини

Якість сну та дотримання стабільного режиму мають набагато більший вплив на здоров’я, ніж вважалося раніше, повідомляє poradnica.com. Вчені дійшли висновку, що розлади сну прямо пов’язані з ризиком розвитку 172 різних захворювань — від метаболічних до неврологічних. До таких висновків дійшли науковці, проаналізувавши дані близько 90 тисяч учасників британського біобанку UK Biobank, що були оприлюднені в журналі Health Data Science.

Дослідження вирізняється своєю точністю: замість традиційних опитувальників, учасники носили спеціальні акселерометри протягом у середньому 6,8 років. Ці пристрої безперервно фіксували показники сну — його тривалість, регулярність, стабільність та кількість нічних пробуджень. Такий підхід дозволив отримати об’єктивну інформацію про справжній стан сну.
Результати вразили: нерегулярний сон може збільшити ймовірність серйозних захворювань у 2 рази і більше. Наприклад, люди, які засинають після пів на першу ночі, мають у 2,5 раза вищий ризик цирозу печінки, ніж ті, хто лягає близько 23:00. А нестабільність у графіку сну значно підвищує ймовірність розвитку гангрени, гострої ниркової недостатності та навіть хвороби Паркінсона.
Особливу тривогу викликає те, що майже половина усіх виявлених асоціацій була пов’язана саме з порушенням циркадного ритму — тобто зі збоєм у звичному розпорядку засинання та пробудження. Цей аспект раніше часто ігнорували, адже більшість досліджень ґрунтувалася на суб’єктивних відповідях учасників, а не на фізичних вимірюваннях.
Крім того, було виявлено, що нестача якісного сну може бути пов’язана із запальними процесами в організмі. У тих, хто страждає від хронічних проблем зі сном, часто спостерігали підвищені рівні С-реактивного білка та лейкоцитів у крові — що може вказувати на системне запалення.
Науковці наголошують: для підтримки доброго здоров’я недостатньо просто «доспати» вихідними. Потрібно щодня дотримуватись чіткого режиму, уникати нічних пробуджень і не нехтувати якістю відпочинку.